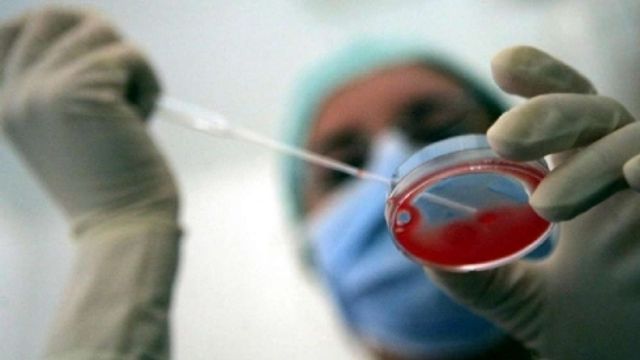

Tra lunedì e mercoledì della prossima settimana anche l'Emilia-Romagna recepirà le linee guida per la fecondazione eterologa approvate giovedì. Le coppie potranno inserirsi nelle liste di attesa. L'assessore alle Politiche per la Salute, Carlo Lusenti, ha spiegato che nelle strutture sanitarie pubbliche sarà gratuita. Si farà in tutti i 21 centri che già effettuano la procreazione medicalmente assistita.
Continua a leggere su tgcom24